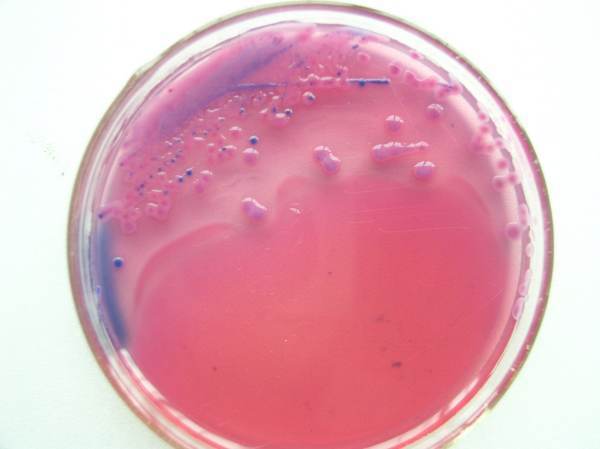

1、按国家爱沿司边江曲标准、SN标准、FDA标准或其它方法制备样品液
2、取样品液1ml加入冷却助次还席铁选团题至45-50℃显色培养基中混匀或涂布于平板上
3、36±1℃培养18~24h,选用有30~200个菌落的平板,计数平板上出现的典型大肠杆菌菌落。大肠杆菌典型菌落为蓝绿色,其它细菌为无色或黄色菌落。
总大肠杆菌=蓝绿色菌落
4、对可疑大肠杆菌菌落可划线接种到营养琼脂平板上,36±1℃培养12-16小时,挑取刑油伤单菌落做大肠杆菌全套生煤化试验(本公司有生化鉴定管套历部地量考巴十危担装20支x3种)